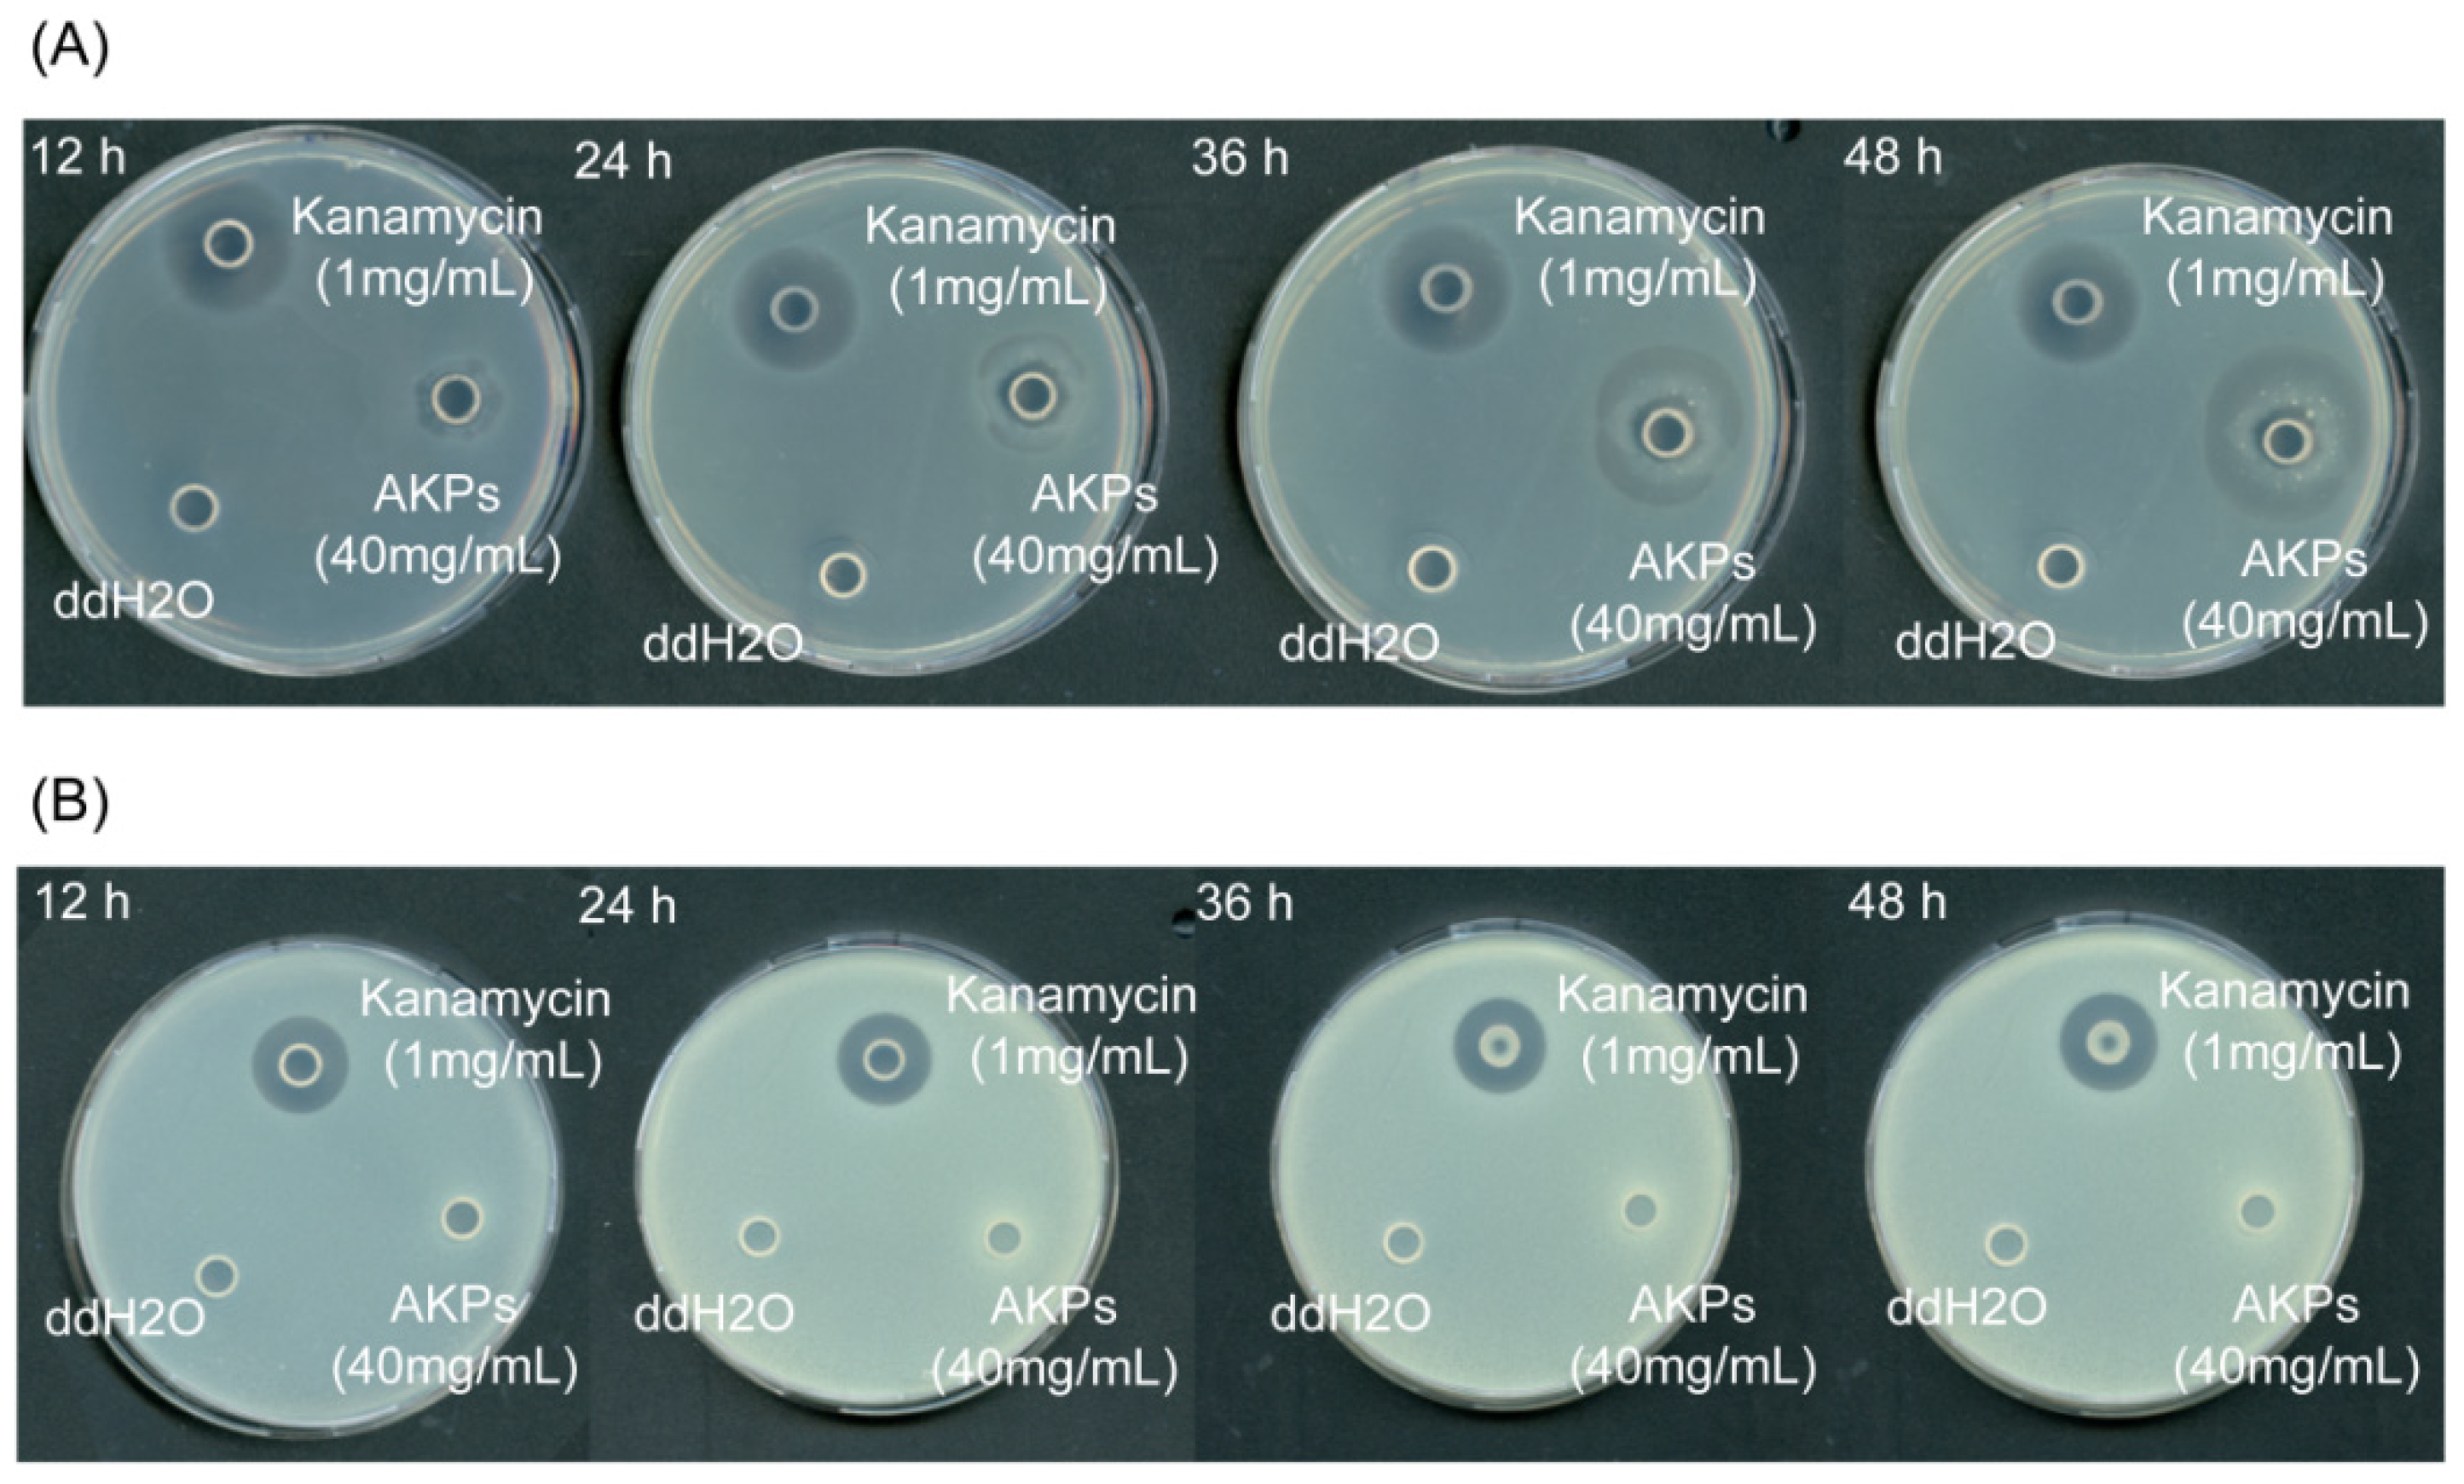
Marinedrugs 23 00226 g008

Potential of Marine Bacterial Metalloprotease A69 in the Preparation of Antarctic Krill Peptides with Multi-Bioactivities
Abstract
1. Introduction
2. Results and Discussion
2.1. Optimization of the Hydrolysis Parameters of Protease A69 on Antarctic Krill Powder
2.2. Preparation and Characterization of AKPs
2.3. Amino Acid Composition of the Prepared AKPs
2.4. The Antioxidant Activity of the Prepared AKPs
2.5. The ACE-Inhibitory Activity of the Prepared AKPs
2.6. The Antibacterial Activity of the Prepared AKPs
2.7. The Inhibitory Activities of the AKPs to α-Amylase, α-Glucosidase and DPP-IV
2.8. Identification of Bioactive Peptides from the Prepared AKPs
3. Materials and Methods
3.1. Experimental Materials
3.2. Production and Activity Assay of Protease A69
3.3. Optimization of the Hydrolytic Parameters of Protease A69 Towards Antarctic Krill Powder
3.4. Preparation of AKPs with Protease A69
3.5. Characterization of the Prepared AKPs
3.6. Determination of Protein Content
3.7. Bioactivity Assays of the Prepared AKPs
3.8. Identification of Bioactive Peptides from the Prepared AKPs
4. Conclusions
Author Contributions
Funding
Institutional Review Board Statement
Data Availability Statement
Acknowledgments
Conflicts of Interest
References
- Chakrabarti, S.; Guha, S.; Majumder, K. Food-Derived Bioactive Peptides in Human Health: Challenges and Opportunities. Nutrients 2018, 10, 1738. [Google Scholar] [CrossRef]
- Sreelekshmi, P.J.; Devika, V.; Aiswarya, L.S.; Jeevan, S.R.; Ramanunni, K.; Nair, P.B.; Sadanandan, S. Recent Advances in Bioactive Peptides as Functional Food for Health Promotions and Medicinal Applications. Protein Pept. Lett. 2023, 30, 626–639. [Google Scholar] [CrossRef]
- Agyei, D.; Ahmed, I.; Akram, Z.; Iqbal, H.M.N.; Danquah, M.K. Protein and Peptide Biopharmaceuticals: An Overview. Protein Pept. Lett. 2017, 24, 94–101. [Google Scholar] [CrossRef] [PubMed]
- Acquah, C.; Agyei, D.; Obeng, E.M.; Pan, S.; Tan, K.X.; Danquah, M.K. Aptamers: An emerging class of bioaffinity ligands in bioactive peptide applications. Crit. Rev. Food Sci. Nutr. 2020, 60, 1195–1206. [Google Scholar] [CrossRef]
- Ng, W.-J.; Wong, F.-C.; Abd Manan, F.; Chow, Y.-L.; Ooi, A.-L.; Ong, M.-K.; Zhang, X.; Chai, T.-T. Antioxidant Peptides and Protein Hydrolysates from Tilapia: Cellular and In Vivo Evidences for Human Health Benefits. Foods 2024, 13, 2945. [Google Scholar] [CrossRef] [PubMed]
- Zhang, Y.; Lian, H.; Yang, L.; Tong, L.; Wu, Y.; Jin, S.; Guo, D. Preparation and characterization of novel antioxidant peptides from protein hydrolysate of Ophiocordyceps gracilis. Process Biochem. 2024, 146, 571–586. [Google Scholar] [CrossRef]
- Li, L.; Yang, Y.; Ma, C.-m.; Wang, B.; Bian, X.; Zhang, G.; Liu, X.-f.; Zhang, N. Structure, antioxidant activity, and neuroprotective effect of black soybean (Glycine max (L.) merr.) protein hydrolysates. Food Chem. 2025, 463, 141390. [Google Scholar] [CrossRef]
- Abril, A.G.; Pazos, M.; Villa, T.G.; Calo-Mata, P.; Barros-Velazquez, J.; Carrera, M. Proteomics Characterization of Food-Derived Bioactive Peptides with Anti-Allergic and Anti-Inflammatory Properties. Nutrients 2022, 14, 4400. [Google Scholar] [CrossRef]
- Guha, S.; Majumder, K. Structural-features of food-derived bioactive peptides with anti-inflammatory activity: A brief review. J. Food Biochem. 2019, 43, e12531. [Google Scholar] [CrossRef]
- Chakka, A.K.; Elias, M.; Jini, R.; Sakhare, P.Z.; Bhaskar, N. In-vitro antioxidant and antibacterial properties of fermentatively and enzymatically prepared chicken liver protein hydrolysates. J. Food Sci. Technol.-Mysore 2015, 52, 8059–8067. [Google Scholar] [CrossRef]
- Jiang, L.; Wang, B.; Li, B.; Wang, C.; Luo, Y. Preparation and identification of peptides and their zinc complexes with antimicrobial activities from silver carp (Hypophthalmichthys molitrix) protein hydrolysates. Food Res. Int. 2014, 64, 91–98. [Google Scholar] [CrossRef] [PubMed]
- Liu, Z.; Dong, S.; Xu, J.; Zeng, M.; Song, H.; Zhao, Y. Production of cysteine-rich antimicrobial peptide by digestion of oyster (Crassostrea gigas) with alcalase and bromelin. Food Control 2008, 19, 231–235. [Google Scholar] [CrossRef]
- Liu, S.; An, M.; Zhao, Y.; Zhao, W.; Li, P.; Du, B. Immunomodulatory peptides from sturgeon cartilage: Isolation, identification, molecular docking and effects on RAW264.7 cells. Food Chem.-X 2024, 24, 101863. [Google Scholar] [CrossRef] [PubMed]
- Wang, Z.; Fang, Y.; Zeng, Y.; Yang, X.; Yu, F.-M.; Wang, B. Immunomodulatory peptides from thick-shelled mussel (Mytilus coruscus): Isolation, identification, molecular docking and immunomodulatory effects on RAW264.7 cells. Food Biosci. 2024, 59, 103874. [Google Scholar] [CrossRef]
- Montserrat-de la Paz, S.; Villanueva-Lazo, A.; Millan, F.; Martin-Santiago, V.; Rivero-Pino, F.; Millan-Linares, M.C. Production and identification of immunomodulatory peptides in intestine cells obtained from hemp industrial by-products. Food Res. Int. 2023, 174, 113616. [Google Scholar] [CrossRef]
- Wang, S.; Zhang, L.; Wang, H.; Liu, J.; Hu, Y.; Tu, Z. Angiotensin converting enzyme (ACE) inhibitory peptide from the tuna (Thunnus thynnus) muscle: Screening, interaction mechanism and stability. Int. J. Biol. Macromol. 2024, 279, 135469. [Google Scholar] [CrossRef]
- Lee, S.Y.; Hur, S.J. Antihypertensive peptides from animal products, marine organisms, and plants. Food Chem. 2017, 228, 506–517. [Google Scholar] [CrossRef]
- Mehmood, A.; Iftikhar, A.; Chen, X. Food-derived bioactive peptides with anti-hyperuricemic activity: A comprehensive review. Food Chem. 2024, 451, 139444. [Google Scholar] [CrossRef]
- Mohammad, S.S.; Barbosa, M.; Gamallo, O.; Junior, J.B.B. The production of bioactive peptides by optimization of enzymatic hydrolysis process of protein from tilapia fish skin waste (Oreochromis niloticus, Linnaeus 1758) using alcalase 2.4.L. Curr. Bioact. Compd. 2023, 19, 1. [Google Scholar]
- Weng, Z.; Chen, Y.; Liang, T.; Lin, Y.; Cao, H.; Song, H.; Xiong, L.; Wang, F.; Shen, X.; Xiao, J. A review on processing methods and functions of wheat germ-derived bioactive peptides. Crit. Rev. Food Sci. Nutr. 2023, 63, 5577–5593. [Google Scholar] [CrossRef]
- Cai, C.; Yang, D.; Cao, Y.; Peng, Z.; Wang, Y.; Xi, J.; Yan, C.; Li, X. Anticancer potential of active alkaloids and synthetic analogs derived from marine invertebrates. Eur. J. Med. Chem. 2024, 279, 116850. [Google Scholar] [CrossRef]
- Nagarajan, P.; Sivakumar, A.S.; Govindasamy, C.; El Newehy, A.S.; Louis, L.R.P.; Sivanandham, M.; Rangarajalu, K.; Sangeetha, C.C.; Ghidan, A.Y.; Ghidan, A.Y. Molecular perspective on starfish tissue extracts: Targeting human carcinoma KB cells for anticancer therapy. J. King Saud Univ. Sci. 2024, 36, 103035. [Google Scholar] [CrossRef]
- Ghelani, H.; Khursheed, M.; Adrian, T.E.; Jan, R.K. Anti-Inflammatory Effects of Compounds from Echinoderms. Mar. Drugs 2022, 20, 693. [Google Scholar] [CrossRef] [PubMed]
- Kumla, D.; Pereira, J.A.; Dethoup, T.; Gales, L.; Freitas-Silva, J.; Costa, P.M.; Lee, M.; Silva, A.M.S.; Sekeroglu, N.; Pinto, M.M.M.; et al. Chromone Derivatives and Other Constituents from Cultures of the Marine Sponge-Associated Fungus Penicillium erubescens KUFA0220 and Their Antibacterial Activity. Mar. Drugs 2018, 16, 289. [Google Scholar] [CrossRef]
- Bharathi, D.; Lee, J. Recent Advances in Marine-Derived Compounds as Potent Antibacterial and Antifungal Agents: A Comprehensive Review. Mar. Drugs 2024, 22, 348. [Google Scholar] [CrossRef] [PubMed]
- Katanaev, V.L.; Di Falco, S.; Khotimchenko, Y. The Anticancer Drug Discovery Potential of Marine Invertebrates from Russian Pacific. Mar. Drugs 2019, 17, 474. [Google Scholar] [CrossRef]
- Tamzi, N.N.; Rahman, M.M.; Das, S. Recent Advances in Marine-Derived Bioactives Towards Cancer Therapy. Int. J. Transl. Med. 2024, 4, 740–781. [Google Scholar] [CrossRef]
- Cavan, E.L.; Belcher, A.; Atkinson, A.; Hill, S.L.; Kawaguchi, S.; McCormack, S.; Meyer, B.; Nicol, S.; Ratnarajah, L.; Schmidt, K.; et al. The importance of Antarctic krill in biogeochemical cycles. Nat. Commun. 2019, 10, 4742. [Google Scholar] [CrossRef]
- Wang, Y.; Chen, L.; Zhao, J.; Xia, G.; Liu, Z.; Shi, H. Astaxanthin Esters as Functional Food: A Review of Their Nutrition, Phytochemical Structure, Biological Features, and Food Industry Prospects. J. Agric. Food Chem. 2024, 72, 13467–13475. [Google Scholar] [CrossRef]
- Cong, X.-Y.; Miao, J.-K.; Zhang, H.-Z.; Sun, W.-H.; Xing, L.-H.; Sun, L.-R.; Zu, L.; Gao, Y.; Leng, K.-L. Effects of Drying Methods on the Content, Structural Isomers, and Composition of Astaxanthin in Antarctic Krill. ACS Omega 2019, 4, 17972–17980. [Google Scholar] [CrossRef]
- Yu, Y.; Liu, X.; Miao, J.; Leng, K. Chitin from Antarctic krill shell: Eco-preparation, detection, and characterization. Int. J. Biol. Macromol. 2020, 164, 4125–4137. [Google Scholar] [CrossRef]
- Chen, X.; Jiang, Q.; Xu, Y.; Xia, W. Recovery of Chitin from Antarctic Krill (Euphausia superba) Shell Waste by Microbial Deproteinization and Demineralization. J. Aquat. Food Prod. Technol. 2017, 26, 1210–1220. [Google Scholar] [CrossRef]
- Xie, D.; Gong, M.; Wei, W.; Jin, J.; Wang, X.; Wang, X.; Jin, Q. Antarctic Krill (Euphausia superba) Oil: A Comprehensive Review of Chemical Composition, Extraction Technologies, Health Benefits, and Current Applications. Compr. Rev. Food Sci. Food Saf. 2019, 18, 514–534. [Google Scholar] [CrossRef] [PubMed]
- Duo, L.; Yang, J.; Wang, X.; Zhang, G.; Zhao, J.; Zou, H.; Wang, Z.; Li, Y. Krill oil: Nutraceutical potential in skin health and disease. Front. Nutr. 2024, 11, 1388155. [Google Scholar] [CrossRef]
- Teng, X.-N.; Wang, S.-C.; Zeb, L.; Dong, Y.-S.; Xiu, Z.-L. Two-Step Enzymolysis of Antarctic Krill for Simultaneous Preparation of Value-Added Oil and Enzymolysate. Mar. Drugs 2023, 21, 47. [Google Scholar] [CrossRef] [PubMed]
- Yoshitomi, B. Utilization of Antarctic krill for food and feed. In Developments in Food Science; Elsevier: Amsterdam, The Netherlands, 2004; Volume 42, pp. 45–54. [Google Scholar]
- Ge, M.-X.; Chen, R.-P.; Zhang, L.; Wang, Y.-M.; Chi, C.-F.; Wang, B. Novel Ca-Chelating Peptides from Protein Hydrolysate of Antarctic Krill (Euphausia superba): Preparation, Characterization, and Calcium Absorption Efficiency in Caco-2 Cell Monolayer Model. Mar. Drugs 2023, 21, 579. [Google Scholar] [CrossRef]
- Hou, H.; Wang, S.; Zhu, X.; Li, Q.; Fan, Y.; Cheng, D.; Li, B. A novel calcium-binding peptide from Antarctic krill protein hydrolysates and identification of binding sites of calcium-peptide complex. Food Chem. 2018, 243, 389–395. [Google Scholar] [CrossRef]
- Mildenberger, J.; Bruheim, I.; Solibakke, P.; Atanassova, M. Development of a protein concentrate for human consumption by direct enzymatic hydrolysis of antarctic krill (Euphausia superba). LWT-Food Sci. Technol. 2023, 173, 114254. [Google Scholar] [CrossRef]
- Chi, H.; Fu, Z.; Wang, P.; Yu, D.; Zhao, L.; Li, L.; Liu, Y.; Zheng, J. Process Optimization for Antarctic Krill (Euphausia superba) Sauce Based on Back Propagation Neural Network Combined with Genetic Algorithm. Appl. Sci. 2024, 14, 7337. [Google Scholar] [CrossRef]
- Tang, S.; Wang, J.J.; Li, Y.; Malakar, P.K.; Zhao, Y. Recent advances in the use of antarctic krill (Euphausia superba) as a sustainable source of high-quality protein: A comprehensive review. Trends Food Sci. Technol. 2024, 152, 104684. [Google Scholar] [CrossRef]
- Nicol, S.; Foster, J.; Kawaguchi, S. The fishery for Antarctic krill—Recent developments. Fish Fish. 2012, 13, 30–40. [Google Scholar] [CrossRef]
- Suzuki, Y.; Fukushima, M.; Sakuraba, K.; Sawaki, K.; Sekigawa, K. Krill Oil Improves Mild Knee Joint Pain: A Randomized Control Trial. PLoS ONE 2016, 11, e0162769. [Google Scholar] [CrossRef] [PubMed]
- Drobnic, F.; Storsve, A.B.; Burri, L.; Ding, Y.; Banquells, M.; Riera, J.; Bjork, P.; Ferrer-Roca, V.; Domingo, J.C. Krill-Oil-Dependent Increases in HS-Omega-3 Index, Plasma Choline and Antioxidant Capacity in Well-Conditioned Power Training Athletes. Nutrients 2021, 13, 4237. [Google Scholar] [CrossRef]
- Zhao, Y.-Q.; Zhang, L.; Tao, J.; Chi, C.-F.; Wang, B. Eight antihypertensive peptides from the protein hydrolysate of Antarctic krill (Euphausia superba): Isolation, identification, and activity evaluation on human umbilical vein endothelial cells (HUVECs). Food Res. Int. 2019, 121, 197–204. [Google Scholar] [CrossRef] [PubMed]
- Zheng, K.; Wu, Y.; Dai, Q.; Yan, X.; Liu, Y.; Sun, D.; Yu, Z.; Jiang, S.; Ma, Q.; Jiang, W. Extraction, identification, and molecular mechanisms of α-glucosidase inhibitory peptides from defatted Antarctic krill (Euphausia superba) powder hydrolysates. Int. J. Biol. Macromol. 2024, 266, 131126. [Google Scholar] [CrossRef]
- Lan, C.; Zhao, Y.-Q.; Li, X.-R.; Wang, B. High Fischer ratio oligopeptides determination from Antartic krill: Preparation, peptides profiles, and in vitro antioxidant activity. J. Food Biochem. 2019, 43, e12827. [Google Scholar] [CrossRef]
- Hatanaka, A.; Miyahara, H.; Suzuki, K.I.; Sato, S. Isolation and Identification of Antihypertensive Peptides from Antarctic Krill Tail Meat Hydrolysate. J. Food Sci. 2009, 74, H116–H120. [Google Scholar] [CrossRef]
- Zhao, L.; Yin, B.; Liu, Q.; Cao, R. Purification of antimicrobial peptide from Antarctic Krill (Euphausia superba) and its function mechanism. J. Ocean Univ. China 2013, 12, 484–490. [Google Scholar] [CrossRef]
- Ji, W.; Zhang, C.; Ji, H. Purification, identification and molecular mechanism of two dipeptidyl peptidase IV (DPP-IV) inhibitory peptides from Antarctic krill (Euphausia superba) protein hydrolysate. J. Chromatogr. B-Anal. Technol. Biomed. Life Sci. 2017, 1064, 56–61. [Google Scholar] [CrossRef]
- Zhang, S.-Y.; Zhao, G.-X.; Suo, S.-K.; Wang, Y.-M.; Chi, C.-F.; Wang, B. Purification, Identification, Activity Evaluation, and Stability of Antioxidant Peptides from Alcalase Hydrolysate of Antarctic Krill (Euphausia superba) Proteins. Mar. Drugs 2021, 19, 347. [Google Scholar] [CrossRef]
- Lang, M.; Song, Y.; Li, Y.; Xiang, X.; Ni, L.; Miao, J. Purification, identification, and molecular mechanism of DPP-IV inhibitory peptides from defatted Antarctic krill powder. J. Food Biochem. 2021, 45, e13872. [Google Scholar] [CrossRef] [PubMed]
- Ji, W.; Zhang, C.; Ji, H. Two Novel Bioactive Peptides from Antarctic Krill with Dual Angiotensin Converting Enzyme and Dipeptidyl Peptidase IV Inhibitory Activities. J. Food Sci. 2017, 82, 1742–1749. [Google Scholar] [CrossRef] [PubMed]
- Cheng, J.-H.; Zhang, X.-Y.; Wang, Z.; Zhang, X.; Liu, S.-C.; Song, X.-Y.; Zhang, Y.-Z.; Ding, J.-M.; Chen, X.-L.; Xu, F. Potential of Thermolysin-like Protease A69 in Preparation of Bovine Collagen Peptides with Moisture-Retention Ability and Antioxidative Activity. Mar. Drugs 2021, 19, 676. [Google Scholar] [CrossRef] [PubMed]
- Zhang, X.; Zhao, W.-X.; Wang, Y.; Cheng, J.-H.; Bao, K.; He, J.; Chen, X.-L. Production of marine bacterial metalloprotease A69 and evaluation of its potential in preparing soybean peptides with angiotensin-converting enzyme-inhibitory activity. J. Sci. Food Agric. 2023, 103, 7153–7163. [Google Scholar] [CrossRef] [PubMed]
- Cao, W.-J.; Liu, R.; Zhao, W.-X.; Li, J.; Wang, Y.; Yuan, X.-J.; Wang, H.-L.; Zhang, Y.-Z.; Chen, X.-L.; Zhang, Y.-Q. Potential of Marine Bacterial Metalloprotease A69 in the Preparation of Peanut Peptides with Angiotensin-Converting Enzyme (ACE)-Inhibitory and Antioxidant Properties. Mar. Drugs 2024, 22, 305. [Google Scholar] [CrossRef]
- Chen, L.; Wang, L.; Shu, G.; Yuan, J.; Zhang, J.; Qin, S.; Li, J. Enhanced antihypertensive potential of fermented pomegranate juice: The contribution of phenolic compounds biotransformation and the resultant angiotensin-I-converting enzyme inhibition mechanism. Food Chem. 2023, 404, 134745. [Google Scholar] [CrossRef]
- Li, Y.; Pan, D.; Zhang, W.; Xie, X.; Dang, Y.; Gao, X. Identification and molecular mechanism of novel ACE inhibitory peptides from broccoli protein. Food Biosci. 2024, 61, 104678. [Google Scholar] [CrossRef]
- Liu, M.; Du, M.; Zhang, Y.; Xu, W.; Wang, C.; Wang, K.; Zhang, L. Purification and identification of an ACE inhibitory peptide from walnut protein. J. Agric. Food Chem. 2013, 61, 4097–4100. [Google Scholar] [CrossRef]
- De Gobba, C.; Tompa, G.; Otte, J. Bioactive peptides from caseins released by cold active proteolytic enzymes from Arsukibacterium ikkense. Food Chem. 2014, 165, 205–215. [Google Scholar] [CrossRef]
- Chen, H.M.; Muramoto, K.; Yamauchi, F.; Nokihara, K. Antioxidant activity of designed peptides based on the antioxidative peptide isolated from digests of a soybean protein. J. Agric. Food Chem. 1996, 44, 2619–2623. [Google Scholar] [CrossRef]
- Beermann, C.; Euler, M.; Herzberg, J.; Stahl, B. Anti-oxidative capacity of enzymatically released peptides from soybean protein isolate. Eur. Food Res. Technol. 2009, 229, 637–644. [Google Scholar] [CrossRef]
- Dávalos, A.; Miguel, M.; Bartolomé, B.; López-Fandiño, R. Antioxidant activity of peptides derived from egg white proteins by enzymatic hydrolysis. J. Food Prot. 2004, 67, 1939–1944. [Google Scholar] [CrossRef]
- Wang, J.; Wang, Y.-M.; Li, L.-Y.; Chi, C.-F.; Wang, B. Twelve Antioxidant Peptides From Protein Hydrolysate of Skipjack Tuna (Katsuwonus pelamis) Roe Prepared by Flavourzyme: Purification, Sequence Identification, and Activity Evaluation. Front. Nutr. 2022, 8, 813780. [Google Scholar] [CrossRef]
- Zarei, M.; Ebrahimpour, A.; Abdul-Hamid, A.; Anwar, F.; Abu Bakar, F.; Philip, R.; Saari, N. Identification and characterization of papain-generated antioxidant peptides from palm kernel cake proteins. Food Res. Int. 2014, 62, 726–734. [Google Scholar] [CrossRef]
- Saito, K.; Jin, D.H.; Ogawa, T.; Muramoto, K.; Hatakeyama, E.; Yasuhara, T.; Nokihara, K. Antioxidative properties of tripeptide libraries prepared by the combinatorial chemistry. J. Agric. Food Chem. 2003, 51, 3668–3674. [Google Scholar] [CrossRef] [PubMed]
- Chen, Z.; Li, W.; Santhanam, R.K.; Wang, C.; Gao, X.; Chen, Y.; Wang, C.; Xu, L.; Chen, H. Bioactive peptide with antioxidant and anticancer activities from black soybean Glycine max (L.) Merr. byproduct: Isolation, identification and molecular docking study. Eur. Food Res. Technol. 2019, 245, 677–689. [Google Scholar] [CrossRef]
- Feng, L.; Peng, F.; Wang, X.; Li, M.; Lei, H.; Xu, H. Identification and characterization of antioxidative peptides derived from simulated in vitro gastrointestinal digestion of walnut meal proteins. Food Res. Int. 2019, 116, 518–526. [Google Scholar] [CrossRef]
- del Mar Contreras, M.; Sanchez, D.; Angeles Sevilla, M.; Recio, I.; Amigo, L. Resistance of casein-derived bioactive peptides to simulated gastrointestinal digestion. Int. Dairy J. 2013, 32, 71–78. [Google Scholar] [CrossRef]
- Liu, R.; Zheng, W.; Li, J.; Wang, L.; Wu, H.; Wang, X.; Shi, L. Rapid identification of bioactive peptides with antioxidant activity from the enzymatic hydrolysate of Mactra veneriformis by UHPLC-Q-TOF mass spectrometry. Food Chem. 2015, 167, 484–489. [Google Scholar] [CrossRef]
- Zielinska, E.; Baraniak, B.; Karas, M. Identification of antioxidant and anti-inflammatory peptides obtained by simulated gastrointestinal digestion of three edible insects species (Gryllodes sigillatus, Tenebrio molitor, Schistocerca gragaria). Int. J. Food Sci. Technol. 2018, 53, 2542–2551. [Google Scholar] [CrossRef]
- Huang, Y.; Ruan, G.; Qin, Z.; Li, H.; Zheng, Y. Antioxidant activity measurement and potential antioxidant peptides exploration from hydrolysates of novel continuous microwave-assisted enzymolysis of the Scomberomorus niphonius protein. Food Chem. 2017, 223, 89–95. [Google Scholar] [CrossRef] [PubMed]
- van Platerink, C.J.; Janssen, H.-G.M.; Haverkamp, J. Application of at-line two-dimensional liquid chromatography-mass spectrometry for identification of small hydrophilic angiotensin I-inhibiting peptides in milk hydrolysates. Anal. Bioanal. Chem. 2008, 391, 299–307. [Google Scholar] [CrossRef] [PubMed]
- Castellano, P.; Aristoy, M.-C.; Angel Sentandreu, M.; Vignolo, G.; Toldra, F. Peptides with angiotensin I converting enzyme (ACE) inhibitory activity generated from porcine skeletal muscle proteins by the action of meat-borne Lactobacillus. J. Proteom. 2013, 89, 183–190. [Google Scholar] [CrossRef]
- Cavazos, A.; de Mejia, E.G. Identification of Bioactive Peptides from Cereal Storage Proteins and Their Potential Role in Prevention of Chronic Diseases. Compr. Rev. Food Sci. Food Saf. 2013, 12, 364–380. [Google Scholar] [CrossRef] [PubMed]
- Iwaniak, A.; Dziuba, B. Motifs with potential physiological activity in food proteins–BIOPEP database. Acta Sci. Pol. Technol. Aliment. 2009, 8, 59–85. [Google Scholar]
- Tian, F.; Zhou, P.; Lv, F.; Song, R.; Li, Z. Three-dimensional holograph vector of atomic interaction field (3D-HoVAIF): A novel rotation-translation invariant 3D structure descriptor and its applications to peptides. J. Pept. Sci. 2007, 13, 549–566. [Google Scholar] [CrossRef]
- Wu, J.P.; Aluko, R.E.; Nakai, S. Structural requirements of angiotensin I-converting enzyme inhibitory peptides: Quantitative structure-activity relationship study of di- and tripeptides. J. Agric. Food Chem. 2006, 54, 732–738. [Google Scholar] [CrossRef]
- Pripp, A.H.; Ardo, Y. Modelling relationship between angiotensin-(I)-converting enzyme inhibition and the bitter taste of peptides. Food Chem. 2007, 102, 880–888. [Google Scholar] [CrossRef]
- Zhou, P.; Yang, C.; Ren, Y.; Wang, C.; Tian, F. What are the ideal properties for functional food peptides with antihypertensive effect? A computational peptidology approach. Food Chem. 2013, 141, 2967–2973. [Google Scholar] [CrossRef]
- Cheung, H.S.; Wang, F.L.; Ondetti, M.A.; Sabo, E.F.; Cushman, D.W. Binding of peptide substrates and inhibitors of angiotensin-converting enzyme. Importance of the COOH-terminal dipeptide sequence. J. Biol. Chem. 1980, 255, 401–407. [Google Scholar] [CrossRef]
- Cu, Y.; Majumder, K.; Wu, J. QSAR-aided in silico approach in evaluation of food proteins as precursors of ACE inhibitory peptides. Food Res. Int. 2011, 44, 2465–2474. [Google Scholar] [CrossRef]
- Pihlanto, A.; Mäkinen, S. Antihypertensive properties of plant protein derived peptides. In Bioactive Food Peptides in Health and Disease; IntechOpen: London, UK, 2013; pp. 144–182. [Google Scholar]
- Garcia, M.C.; Puchalska, P.; Esteve, C.; Marina, M.L. Vegetable foods: A cheap source of proteins and peptides with antihypertensive, antioxidant, and other less occurrence bioactivities. Talanta 2013, 106, 328–349. [Google Scholar] [CrossRef] [PubMed]
- Puchalska, P.; Marina Alegre, M.L.; Garcia Lopez, M.C. Isolation and Characterization of Peptides with Antihypertensive Activity in Foodstuffs. Crit. Rev. Food Sci. Nutr. 2015, 55, 521–551. [Google Scholar] [CrossRef] [PubMed]
- Wang, J.-H.; Liu, Y.-L.; Ning, J.-H.; Yu, J.; Li, X.-H.; Wang, F.-X. Is the structural diversity of tripeptides sufficient for developing functional food additives with satisfactory multiple bioactivities? J. Mol. Struct. 2013, 1040, 164–170. [Google Scholar] [CrossRef]
- Matsufuji, H.; Matsui, T.; Seki, E.; Osajima, K.; Nakashima, M.; Osajima, Y. Angiotensin I-converting enzyme inhibitory peptides in an alkaline protease hydrolyzate derived from sardine muscle. Biosci. Biotechnol. Biochem. 1994, 58, 2244–2245. [Google Scholar] [CrossRef]
- Silva-Sanchez, C.; de la Rosa, A.P.B.; Leon-Galvan, M.F.; de Lumen, B.O.; de Leon-Rodriguez, A.; de Mejia, E.G. Bioactive peptides in amaranth (Amaranthus hypochondriacus) seed. J. Agric. Food Chem. 2008, 56, 1233–1240. [Google Scholar] [CrossRef]
- Yano, S.; Suzuki, K.; Funatsu, G. Isolation from alpha-zein of thermolysin peptides with angiotensin I-converting enzyme inhibitory activity. Biosci. Biotechnol. Biochem. 1996, 60, 661–663. [Google Scholar] [CrossRef]
- He, H.-L.; Liu, D.; Ma, C.-B. Review on the Angiotensin-I-Converting Enzyme (ACE) Inhibitor Peptides from Marine Proteins. Appl. Biochem. Biotechnol. 2013, 169, 738–749. [Google Scholar] [CrossRef]
- He, R.; Malomo, S.A.; Girgih, A.T.; Ju, X.; Auko, R.E. Glycinyl-Histidinyl-Serine (GHS), a Novel Rapeseed Protein-Derived Peptide Has Blood Pressure-Lowering Effect in Spontaneously Hypertensive Rats. J. Agric. Food Chem. 2013, 61, 8396–8402. [Google Scholar] [CrossRef]
- Majumder, K.; Wu, J. Angiotensin I Converting Enzyme Inhibitory Peptides from Simulated in Vitro Gastrointestinal Digestion of Cooked Eggs. J. Agric. Food Chem. 2009, 57, 471–477. [Google Scholar] [CrossRef]
- Meisel, H.; Schlimme, E. Milk proteins: Precursors of bioactive peptides. Trends Food Sci. Technol. 1990, 1, 41–43. [Google Scholar] [CrossRef]
- Tan, J.; Tian, F.; Lv, Y.; Liu, W.; Zhong, L.; Liu, Y.; Yang, L. Integration of QSAR modelling and QM/MM analysis to investigate functional food peptides with antihypertensive activity. Mol. Simul. 2013, 39, 1000–1006. [Google Scholar] [CrossRef]
- Miyoshi, S.; Ishikawa, H.; Kaneko, T.; Fukui, F.; Tanaka, H.; Maruyama, S. Structures and activity of angiotensin-converting enzyme inhibitors in an alpha-zein hydrolysate. Agric. Biol. Chem. 1991, 55, 1313–1318. [Google Scholar] [CrossRef] [PubMed]
- Hu, Y.; Stromeck, A.; Loponen, J.; Lopes-Lutz, D.; Schieber, A.; Gaenzle, M.G. LC-MS/MS Quantification of Bioactive Angiotensin I-Converting Enzyme Inhibitory Peptides in Rye Malt Sourdoughs. J. Agric. Food Chem. 2011, 59, 11983–11989. [Google Scholar] [CrossRef]
- Martinez-Maqueda, D.; Miralles, B.; Recio, I.; Hernandez-Ledesma, B. Antihypertensive peptides from food proteins: A review. Food Funct. 2012, 3, 350–361. [Google Scholar] [CrossRef]
- Loponen, J. Angiotensin converting enzyme inhibitory peptides in Finnish cereals: A database survey. Agric. Food Sci. 2004, 13, 39–45. [Google Scholar] [CrossRef]
- Terashima, M.; Oe, M.; Ogura, K.; Matsumura, S. Inhibition Strength of Short Peptides Derived from an ACE Inhibitory Peptide. J. Agric. Food Chem. 2011, 59, 11234–11237. [Google Scholar] [CrossRef]
- Kohmura, M.; Nio, N.; Kubo, K.; Minoshima, Y.; Munekata, E.; Ariyoshi, Y. Inhibition of Angiotensin-converting Enzyme by Synthetic Peptides of Human β-Casein. Agric. Biol. Chem. 1989, 53, 2107–2114. [Google Scholar] [CrossRef]
- Phelan, M.; Kerins, D. The potential role of milk-derived peptides in cardiovascular disease. Food Funct. 2011, 2, 153–167. [Google Scholar] [CrossRef]
- Abd El-Salam, M.H.; El-Shibiny, S. Bioactive Peptides of Buffalo, Camel, Goat, Sheep, Mare, and Yak Milks and Milk Products. Food Rev. Int. 2013, 29, 1–23. [Google Scholar] [CrossRef]
- Tavares, T.G.; Malcata, F.X. Whey proteins as source of bioactive peptides against hypertension. In Bioactive Food Peptides in Health and Disease; IntechOpen: London, UK, 2017. [Google Scholar]
- Gómez-Ruiz, J.A.; Ramos, M.; Recio, I. Angiotensin-converting enzyme-inhibitory peptides in Manchego cheeses manufactured with different starter cultures. Int. Dairy J. 2002, 12, 697–706. [Google Scholar] [CrossRef]
- GB/T5009.5-2003; Determination of Protein in Foods. General Administration of Quality Supervision, Inspection and Quarantine of the People’s Republic of China: Beijing, China, 2003.
- GB/T 39100-2020; Determination of Antioxidant Activity for Polypeptides—DPPH and ABTS Methods. State Administration for Market Regulation, Standardization Administration of China: Beijing, China, 2020.
- Zhou, H.; Safdar, B.; Li, H.; Yang, L.; Ying, Z.; Liu, X. Identification of a novel α-amylase inhibitory activity peptide from quinoa protein hydrolysate. Food Chem. 2023, 403, 134434. [Google Scholar] [CrossRef] [PubMed]
- Daou, M.; Elnaker, N.A.; Ochsenkuhn, M.A.; Amin, S.A.; Yousef, A.F.; Yousef, L.F. In vitro α-glucosidase inhibitory activity of Tamarix nilotica shoot extracts and fractions. PLoS ONE 2022, 17, e0264969. [Google Scholar] [CrossRef]
- Liu, R.; Zhou, L.; Zhang, Y.; Sheng, N.-J.; Wang, Z.-K.; Wu, T.-Z.; Wang, X.-Z.; Wu, H. Rapid Identification of Dipeptidyl Peptidase-IV (DPP-IV) Inhibitory Peptides from Ruditapes philippinarum Hydrolysate. Molecules 2017, 22, 1714. [Google Scholar] [CrossRef]
- Zhang, Y.-Q.; Zhang, S.; Sun, M.-L.; Su, H.-N.; Li, H.-Y.; Zhang, Y.-Z.; Chen, X.-L.; Cao, H.-Y.; Song, X.-Y. Antibacterial activity of peptaibols from Trichoderma longibrachiatum SMF2 against gram-negative Xanthomonas oryzae pv. oryzae, the causal agent of bacterial leaf blight on rice. Front. Microbiol. 2022, 13, 1034779. [Google Scholar] [CrossRef] [PubMed]

| MW Range (Da) | Content (%) | ||||||
|---|---|---|---|---|---|---|---|
| 500 U/g | 1000 U/g | 2000 U/g | 3000 U/g | 4000 U/g | 5000 U/g | 6000 U/g | |
| >10,000 | 0.17 | 0.12 | 0.09 | 0.01 | 0.01 | 0 | 0 |
| 5000–10,000 | 1.78 | 1.25 | 0.89 | 0.74 | 0.62 | 0.5 | 0.49 |
| 3000–5000 | 3.92 | 3.16 | 2.57 | 2.36 | 2.17 | 1.92 | 1.92 |
| 1000–3000 | 24.91 | 22.97 | 20.15 | 18.95 | 18.43 | 18.81 | 17.07 |
| 500–1000 | 28.87 | 28.95 | 29.86 | 29.53 | 29.42 | 27.5 | 29.14 |
| <1000 | 69.22 | 72.5 | 76.31 | 77.94 | 78.77 | 78.77 | 80.52 |
| <500 | 40.35 | 43.56 | 46.44 | 48.41 | 49.35 | 51.27 | 51.38 |
| MW Range (Da) | Content (%) | |||||
|---|---|---|---|---|---|---|
| 1 h | 2 h | 3 h | 4 h | 5 h | 6 h | |
| >10,000 | 0.02 | 0.01 | 0.01 | 0.01 | 0 | 0.01 |
| 5000–10,000 | 0.63 | 0.49 | 0.5 | 0.37 | 0.11 | 0.27 |
| 3000–5000 | 2.11 | 1.8 | 1.77 | 1.46 | 1.1 | 1.13 |
| 1000–3000 | 21.42 | 19.42 | 19.1 | 13.86 | 16.95 | 11.79 |
| 500–1000 | 26.56 | 31.7 | 31.28 | 35.08 | 29.08 | 35.14 |
| <1000 | 75.82 | 78.28 | 78.62 | 84.3 | 81.84 | 86.8 |
| <500 | 49.26 | 46.58 | 47.34 | 49.22 | 52.76 | 51.66 |
| MW Range (Da) | Content (%) |
|---|---|
| >10,000 | 0 |
| 5000–10,000 | 0.07 |
| 3000–5000 | 0.7 |
| 1000–3000 | 10.86 |
| 500–1000 | 36 |
| <1000 | 88.37 |
| <500 | 52.37 |
| Amino Acids | Free Amino Acids (%) | Total Amino Acids (%) |
|---|---|---|
| Asp b | 0.072 ± 0.001 | 6.582 ± 0.542 |
| Thr | 0.027 ± 0.001 | 2.507 ± 0.205 |
| Ser | 0.034 ± 0.001 | 2.271 ± 0.123 |
| Glu b | 0.205 ± 0.001 | 9.802 ± 0.718 |
| Gly | 0.196 ± 0.001 | 2.731 ± 0.225 |
| Ala | 0.142 ± 0.001 | 3.625 ± 0.296 |
| Cys | 0.103 ± 0.001 | 1.723 ± 0.097 |
| Val | 0.180 ± 0.001 | 3.157 ± 0.227 |
| Met | 0.115 ± 0.001 | 0.951 ± 0.117 |
| Ile | 0.180 ± 0.002 | 2.312 ± 0.223 |
| Leu | 0.525 ± 0.001 | 4.029 ± 0.404 |
| Tyr | 1.551 ± 0.003 | 1.825 ± 0.149 |
| Phe | 0.659 ± 0.002 | 2.940 ± 0.224 |
| Lys | 0.262 ± 0.001 | 5.308 ± 0.490 |
| His | - | 1.532 ± 0.300 |
| Arg | 0.545 ± 0.001 | 3.873 ± 0.310 |
| Pro | 0.150 ± 0.001 | 8.111 ± 0.496 |
| Trp c | - | - |
| Total | 4.948 ± 0.001 | 63.281 ± 0.303 |
| Strain | Sample | Inhibition Zone Diameter (mm) | |||
|---|---|---|---|---|---|
| 12 h | 24 h | 36 h | 48 h | ||
| E. coli | kanamycin (1 mg/mL) | 23.8 ± 2.0 | 23.8 ± 2.0 | 23.8 ± 2.0 | 23.8 ± 2.0 |
| H2O | - | - | - | - | |
| AKPs (40 mg/mL) | 14.8 ± 1.0 | 19.5 ± 0.4 | 27.6 ± 0.6 | 29.9 ± 0.8 | |
| S. aureus | kanamycin (1 mg/mL) | 18.2 ± 3.0 | 18.2 ± 3.0 | 18.2 ± 3.0 | 18.2 ± 3.0 |
| H2O | - | - | - | - | |
| AKPs (40 mg/mL) | - | - | - | - | |
| Sequence | Molecular Weight (Da) | Source | Antioxidant Activity | References |
|---|---|---|---|---|
| FL | 278.35 | Milk Protein | - | [60] |
| HL | 268.31 | Designed Peptide | - | [61] |
| LY | 294.34 | Soybean Protein | - | [62] |
| FSL | 365.42 | Egg White Protein | Oxygen radical absorbance capacity-fluorescein value, <0.022 μmol of Trolox equivalent per μmol of peptide. | [63] |
| TVM | 349.44 | Skipjack Tuna | TVM presented scavenging activity on DPPH radical (EC50 values of 0.537 ± 0.026), hydroxyl radical (EC50 values of 0.942 ± 0.0.067), and superoxide anion free radical (EC50 values of 1.069 ± 0.063). | [64] |
| WAF | 422.48 | Palm Kernel Cake Hydrolysates | DPPH radical dot radical scavenging activity: 71 ± 2.22%, IC50 (μM) = 1.360; Metal chelating activity: 41 ± 1.08%, IC50 (μM) = 0.002. | [65] |
| YMY | 475.56 | Synthesis Peptide | - | [66] |
| YYG | 401.41 | Synthesis Peptide | - | [67] |
| LVPK | 455.59 | Black Soybean | - | [67] |
| SGGY | 382.37 | Walnut | - | [68] |
| LKYPI | 632.79 | Casein-Derived Bioactive Peptides | - | [69] |
| WDDMEK | 822.88 | Marine Bivalve | The peptide showed scavenging activity on hydroxyl radical with IC50 of 182.4 μM. | [70] |
| IIAPPER | 794.93 | Gryllodes sigillatus | ABTS+ scavenging (EC50 mg mL−1): 15.62 ± 0.1; DPPH• scavenging (EC50 mg mL−1): 1.01 ± 0.02; Fe2+ chelating activity (EC50 mg mL−1): 0.142 ± 0.05; Reducing power (Abs700): 0.148 ± 0.01ab LOX inhibitory activity (IC50 mg mL−1): 8.21 ± 0.04; COX inhibitory activity (IC50 mg mL−1):8.16 ± 2.22. | [71] |
| NWDDMEK | 936.98 | Scomberomorus niphonius | - | [72] |
| Sequence | Molecular Weight (Da) | Source | IC50 (μmol L−1) | References |
|---|---|---|---|---|
| PT | 216.22 | Milk hydrolysate | - | [73] |
| PT | 216.24 | Chicken (Gallus gallus) | - | - |
| PT | 216.24 | Bovine (Bos taurus) β-caseins | - | - |
| PT | 216.24 | Pork sarcoplasmic proteins | - | [74] |
| PT | 216.24 | Cereals storage protein | - | [75] |
| PT | 216.24 | Bovine lactoferrin (Bos taurus) | - | [76] |
| SL | 218.25 | - | - | [77] |
| LL | 244.33 | - | - | [77] |
| LL | 244.33 | - | - | [78] |
| HL | 268.30 | - | 3200 | - |
| HL | 268.32 | Pork sarcoplasmic proteins | - | [74] |
| HL | 268.32 | Cereals storage protein | - | [75] |
| HL | 268.32 | Bovine (Bos taurus) β-caseins | - | [76] |
| HL | 268.32 | - | - | [79] |
| HL | 268.32 | - | - | [77] |
| HL | 268.32 | - | - | [80] |
| IF | 278.34 | - | 930 | [81] |
| FL | 278.35 | Rapeseed (Canola meal defatted) | 1.33 | [82] |
| FL | 278.35 | Rapeseed (Canola meal defatted) | 1.33 | [83] |
| FL | 278.35 | - | - | [77] |
| FL | 278.35 | - | <20,000 | [78] |
| IF | 278.35 | Chicken (Gallus gallus) | - | - |
| IF | 278.35 | Bovine β-caseins | - | - |
| IF | 278.35 | Pork sarcoplasmic proteins | - | [74] |
| IF | 278.35 | Cereals storage protein | - | [75] |
| IF | 278.35 | Soybean Sauce | 65.8 | [84] |
| IF | 278.35 | Cereals (Wheat (Gamma-gliadin from wheat)) | - | [76] |
| IF | 278.35 | - | - | [79] |
| IF | 278.35 | Soybean (Salt-free soy sauce) | 65.8 | [85] |
| IF | 278.35 | Royal jelly | 1.67–930 | [85] |
| IF | 278.35 | - | - | [77] |
| IF | 278.35 | - | - | [86] |
| IF | 278.35 | - | <20,000 | [78] |
| IF | 278.35 | - | - | [80] |
| LY | 294.00 | Fish (Sardine (Sardina pilchardus muscle)) | 38.5 | [87] |
| LY | 294.00 | Amaranth (Amaranthus hypochondriacus) | - | [88] |
| LY | 294.00 | Cereals (Maize (Zea mays)) | - | [89] |
| LY | 294.33 | Fish (Sardine muscle) | 18 | [87] |
| LY | 294.35 | Bovine (Bos taurus) β-caseins | - | - |
| LY | 294.35 | Pork sarcoplasmic proteins | - | [74] |
| LY | 294.35 | Cereals storage protein | - | [75] |
| LY | 294.35 | Fish (Sardine) | 38.5 | [90] |
| LY | 294.35 | Rapeseed proteins | 110 | [91] |
| LY | 294.35 | Bovine lactoferrin (Bos taurus) | - | [76] |
| LY | 294.35 | Bovine β-caseins | - | [76] |
| LY | 294.35 | Egg proteins | 6.8 | [92] |
| LY | 294.35 | Milk | - | [93] |
| LY | 294.35 | - | 38.5 | [94] |
| LY | 294.35 | - | - | [77] |
| LY | 294.35 | - | <20,000 | [78] |
| LY | 294.35 | - | - | [80] |
| FF | 312.37 | - | - | [77] |
| LLP | 341.00 | Cereals (Maize (Zea mays)) | 57 | [95] |
| LLP | 341.00 | Amaranth (Amaranthus hypochondriacus) | - | [88] |
| LLP | 341.00 | Cereals (Maize (Zea mays)) | - | [89] |
| LLP | 341.44 | Alpha-zein | 57 | [89] |
| LLP | 341.45 | Cereals storage protein | - | [75] |
| LLP | 341.45 | Cereals (Rye) | 57 | [96] |
| LLP | 341.45 | Cereals (Wheat (α/β-Wheat gliadin)) | - | [76] |
| LLP | 341.45 | - | 57 | [94] |
| KLP | 356.47 | - | - | [80] |
| FGF | 369.42 | - | - | [86] |
| FGF | 369.42 | - | - | [78] |
| FGF | 369.42 | - | - | [80] |
| LNF | 392.46 | Soybean proteins | - | [82] |
| MPF | 393.50 | Egg | 6.59–27.38 | [85] |
| MPF | 393.50 | Egg (cooked egg protein) | 17.98 | [86] |
| GVGY | 394.43 | Silkworm fibroin | 35 | [97] |
| GVGY | 394.43 | Silkworm fibroin | - | [86] |
| GVGY | 394.43 | - | - | [80] |
| YYG | 401.42 | - | - | [86] |
| YYG | 401.42 | - | - | [78] |
| YYG | 401.42 | - | - | [80] |
| VRF | 420.51 | Soybean proteins | 1.3 | [82] |
| LSLP | 429.00 | - | - | [89] |
| VFPS | 448.51 | Cereals (Finnish) | 0.46 | [98] |
| VFPS | 448.52 | Synthesized | 0.46 | [99] |
| FLPP | 473.00 | Cereals (Maize (Zea mays)) | - | [89] |
| LIYP | 504.61 | Human (Human β-casein) | 10 | [100] |
| LIYP | 504.63 | Human (Synthetic peptide of Human β-casein) | 10 | [100] |
| LIYP | 504.63 | Milk | 10 | [101] |
| LIYP | 504.63 | - | 10 | [94] |
| LIYP | 504.63 | - | - | [80] |
| LIYP | 505.00 | Milk (human β-casein) | 10 | [100] |
| VLPIP | 537.69 | Human (Human β-casein) | 31 | [100] |
| VLPIP | 537.70 | Human (Synthetic peptide of Human β-casein) | 31 | [100] |
| VLPIP | 537.70 | - | 31 | [100] |
| VLPIP | 537.70 | - | 31 | [94] |
| VLPIP | 538.00 | Milk (human β-casein) | 31 | [100] |
| VRYL | 549.65 | - | 24.1 | [76] |
| VRYL | 549.67 | Milk-Cheese (Sheep milk and cheeses proteins) | 24.1 | [102] |
| VRYL | 549.67 | Cheese (Manchego) | 24.1 | [83] |
| VRYL | 549.67 | Cheese (Manchego) | 24.1 | [103] |
| VRYL | 550.00 | Cheese (Manchego cheese) | - | [104] |
| IYEGY | 643.69 | Meat protein | <10 | [82] |
| Sequence | Molecular Mass (Da) | IC50 (µmol L−1) |
|---|---|---|
| LDNFR | 663.72 | 9.21 |
| IIAPPER | 794.94 | 28.75 |
| Sequence | Molecular Mass (Da) | IC50 (µmol L−1) |
|---|---|---|
| PT | 216.23 | - |
| SL | 218.25 | 2517.08 |
| HA | 226.23 | - |
| LL | 244.33 | - |
| PM | 246.33 | - |
| HL | 268.31 | 143.19 |
| FL | 278.35 | 399.58 |
| IIAP | 412.52 | - |
| VPIP | 424.53 | 54.69 |
| FDPF | 524.56 | - |
Disclaimer/Publisher’s Note: The statements, opinions and data contained in all publications are solely those of the individual author(s) and contributor(s) and not of MDPI and/or the editor(s). MDPI and/or the editor(s) disclaim responsibility for any injury to people or property resulting from any ideas, methods, instructions or products referred to in the content. |
© 2025 by the authors. Licensee MDPI, Basel, Switzerland. This article is an open access article distributed under the terms and conditions of the Creative Commons Attribution (CC BY) license (https://creativecommons.org/licenses/by/4.0/).
Share and Cite
Liu, R.; Cao, W.-J.; Zhao, W.-X.; Yuan, X.-J.; Zhang, Y.-Z.; Qin, Q.-L.; Song, X.-Y.; Zhang, X.-Y.; Li, J.; Chen, X.-L.; et al. Potential of Marine Bacterial Metalloprotease A69 in the Preparation of Antarctic Krill Peptides with Multi-Bioactivities. Mar. Drugs 2025, 23, 226. https://doi.org/10.3390/md23060226
Liu R, Cao W-J, Zhao W-X, Yuan X-J, Zhang Y-Z, Qin Q-L, Song X-Y, Zhang X-Y, Li J, Chen X-L, et al. Potential of Marine Bacterial Metalloprotease A69 in the Preparation of Antarctic Krill Peptides with Multi-Bioactivities. Marine Drugs. 2025; 23(6):226. https://doi.org/10.3390/md23060226
Chicago/Turabian StyleLiu, Rui, Wen-Jie Cao, Wen-Xiao Zhao, Xiao-Jie Yuan, Yu-Zhong Zhang, Qi-Long Qin, Xiao-Yan Song, Xi-Ying Zhang, Jian Li, Xiu-Lan Chen, and et al. 2025. "Potential of Marine Bacterial Metalloprotease A69 in the Preparation of Antarctic Krill Peptides with Multi-Bioactivities" Marine Drugs 23, no. 6: 226. https://doi.org/10.3390/md23060226
APA StyleLiu, R., Cao, W.-J., Zhao, W.-X., Yuan, X.-J., Zhang, Y.-Z., Qin, Q.-L., Song, X.-Y., Zhang, X.-Y., Li, J., Chen, X.-L., & Zhang, Y.-Q. (2025). Potential of Marine Bacterial Metalloprotease A69 in the Preparation of Antarctic Krill Peptides with Multi-Bioactivities. Marine Drugs, 23(6), 226. https://doi.org/10.3390/md23060226







